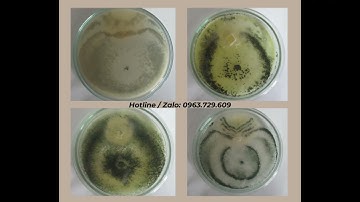
Công dụng của chế phẩm sinh học nấm đối kháng trichoderma

⬇ DOWNLOAD NOW
Kalau muncul iklan pop-up, tutup lalu klik tombol kembali
Download lagu BIMA, chế phẩm sinh học, nấm đối kháng trichoderma, phân bón trichoderma, tri cô đặc ma, trichoderma secara gratis hanya untuk keperluan promosi. Dukung artis favorit kamu dengan membeli musik original di iTunes atau platform resmi lainnya.
 Nấm trichoderma loại nào tốt? 2 loại chế phẩm nấm đối kháng trichoderma Đức Bình tốt nhất hiện nay.
Nấm trichoderma loại nào tốt? 2 loại chế phẩm nấm đối kháng trichoderma Đức Bình tốt nhất hiện nay.
 TRICHODEMA BACILLUS SP ĐƯỢC CÁC NHÀ VƯỜN VÀ ĐẠI LÝ TIN DÙNG, GIÚP PHÂN NHANH HOAI MỤC, CHỐNG NẤM RỄ
TRICHODEMA BACILLUS SP ĐƯỢC CÁC NHÀ VƯỜN VÀ ĐẠI LÝ TIN DÙNG, GIÚP PHÂN NHANH HOAI MỤC, CHỐNG NẤM RỄ
 Vai Trò Quan Trọng của NẤM TRICHODERMA Đối Với Cây Trồng / Bạn của nhà nông
Vai Trò Quan Trọng của NẤM TRICHODERMA Đối Với Cây Trồng / Bạn của nhà nông
Công dụng của chế phẩm sinh học nấm đối kháng trichoderma
Công dụng của chế phẩm sinh học nấm đối kháng trichoderma
 Nấm đối kháng Trichoderma - Những ứng dụng và cơ chế hoạt động của Trichoderma
Nấm đối kháng Trichoderma - Những ứng dụng và cơ chế hoạt động của Trichoderma
 Trichoderma có tác dụng gì? - nông dân cần biết để ủ phân và đối kháng nấm bệnh hiệu quả
Trichoderma có tác dụng gì? - nông dân cần biết để ủ phân và đối kháng nấm bệnh hiệu quả
 Nông dân cần biết-hiểu về nấm trichoderma, cách chọn sản phẩm chất lượng và cách ủ tricho tại nhà.
Nông dân cần biết-hiểu về nấm trichoderma, cách chọn sản phẩm chất lượng và cách ủ tricho tại nhà.
 TRICHODERMA LÀ GÌ ? | NẤM ĐỐI KHÁNG TRICHODERMA BẢO VỆ CÂY TRỒNG | Vlog Nông Nghiệp TKS
TRICHODERMA LÀ GÌ ? | NẤM ĐỐI KHÁNG TRICHODERMA BẢO VỆ CÂY TRỒNG | Vlog Nông Nghiệp TKS